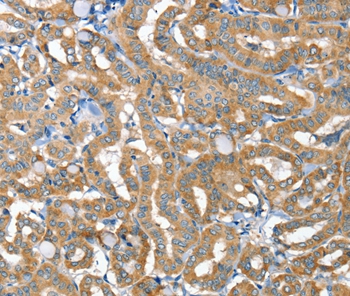
Anti-TNFRSF21 Antibody

TNFRSF21 Polyclonal Antibody
RD76234A
ApplicationsWestern Blot, ELISA
Product group Antibodies
ReactivityHuman
TargetTNFRSF21
Overview
- SupplierReddot Biotech
- Product NameTNFRSF21 Polyclonal Antibody
- Delivery Days Customer5
- ApplicationsWestern Blot, ELISA
- CertificationResearch Use Only
- ClonalityPolyclonal
- Concentration0.3 mg/ml
- ConjugateUnconjugated
- Gene ID27242
- Target nameTNFRSF21
- Target descriptionTNF receptor superfamily member 21
- Target synonymsBM-018, CD358, DR6, tumor necrosis factor receptor superfamily member 21, TNFR-related death receptor 6, death receptor 6
- HostRabbit
- IsotypeIgG
- Scientific DescriptionThe protein encoded by this gene is a member of the TNF-receptor superfamily. This receptor has been shown to activate NF-kappaB and MAPK8/JNK, and induce cell apoptosis. Through its death domain, this receptor interacts with TRADD protein, which is known to serve as an adaptor that mediates signal transduction of TNF-receptors. Knockout studies in mice suggested that this gene plays a role in T-helper cell activation, and may be involved in inflammation and immune regulation.
- ReactivityHuman
- Storage Instruction-20°C
- UNSPSC12352203